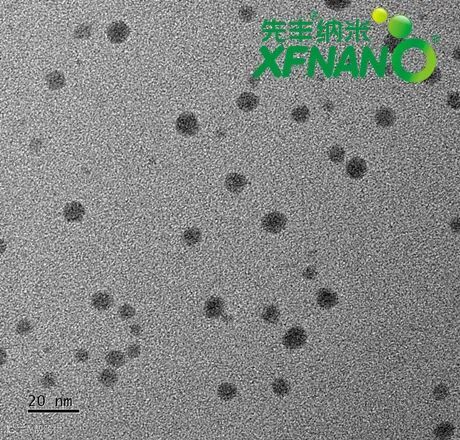

光热治疗(PTT)因其高选择性、最小副作用和精确的时空控制,已成为应对创伤感染的极具前景的方法。近年来,各种光热剂,包括有机光热剂、金属基纳米材料、碳基纳米材料和有机/无机纳米复合材料,已被探索用于破坏细菌的完整性并提供抗生物膜治疗。其中,Ag2S纳米粒子由于优异的光热转化效率和抗光漂白能力,成为理想的生物医学应用材料。
本期小丰整理了3篇Ag2S纳米粒子的光热应用研究进展,一起看下吧~
Chemical Engineering Journal
光刺激双⽹络⽔凝胶⽤于癌症光热治疗
肽类物质因其高设计灵活性、优异的生物相容性及可降解性,在生物材料领域展现出巨大潜力。基于肽的刺激响应型生物材料更赋予了其在药物递送和生物活性调控方面的独特功能。
2025年3月22日,期刊Chemical Engineering Journal报道研究人员创新性地设计了一种基于甲基丙烯酰化肽纳米纤维(PNFMA)的具有高生物相容性、良好生物降解性和多种功能的光刺激双网络水凝胶,将其应用于肿瘤细胞的调控光热治疗。
在该项工作中,研究人员通过光交联实现了甲基丙烯酸化肽和GelMA的可控凝胶化。然后将甲基丙烯酰化肽纳⽶纤维(PNFMA)作为模板,利用静电相互作用固定了均匀分散的硫化银纳米粒子(Ag2S NPs)。通过“智能分⼦组装-光控成型”策略,成功构建了光响应双⽹络⽔凝胶 (GelMA/PNFMA-Ag2S)。自组装多肽纳米纤维(PNFMA)解决了聚集引起的光热效率低下问题,同时提高了生物相容性。
研究发现,该水凝胶表现出快速光控凝胶化的特性,在365nm紫外光照射下,2分钟内实现溶液到凝胶的快速转化。同时⽔凝胶在体外和体内均表现出优异的光热稳定性,光热转换效率⾼达56.6%,对肿瘤细胞的⾼效杀伤作⽤显著。静电驱动的Ag2S NPs固定在PNFMA上,这种协同纳米生物界面形成了 “热点密集 ”的光热网络,而双网络结构抑制了热量散失,从而在2W/cm2的条件下,肿瘤消融率达到99.9%,且无脱靶毒性。
这种光刺激双网络水凝胶不仅在肿瘤光热治疗中展现出巨大潜力,还可应用于刺激响应药物释放、伤口敷料等生物医学领域。
文献名称:Photo-stimulating dual-network microminiature hydrogels reinforced with silver sulfide nanoparticles for regulated cancer photothermal therapy
Advanced Science
Ag2S纳米点基微针贴片用于术后黑色素瘤复发和感染性创伤治疗
在恶性黑色素瘤的手术治疗中,肿瘤切除不彻底和大面积皮肤缺损是导致局部高复发率和伤口感染失控的主要原因,从而导致预后不良和患者康复时间延长。
2025年2月4日,期刊Advanced Science报道研究人员开发了一种多功能纳米复合材料微针贴片,能够同时进行近距离放射治疗和光热治疗,从而为术后黑色素瘤复发和感染性创伤愈合提供增强的辅助治疗。
在该项工作中,研究人员通过两步生物矿化过程将Ag2S纳米点与32P标记的磷酸钙(Ca32P)纳米粒子结合,获得了Ag2S/Ca32P纳米复合材料。接着,利用甲基丙烯酸明胶(GelMA)作为针尖,透明质酸(HA)作为背衬层,构建了微针贴片,将Ag2S/Ca32P递送到浸润的肿瘤细胞和细菌生物膜中。
研究发现,制备的GM-Ag2S/Ca32P微针贴片能够有效穿透皮下组织,将Ag2S/Ca32P递送到靶向部位。当微针贴片到达肿瘤和细菌生物膜的酸性微环境时,Ag2S/Ca32P纳米复合材料会分解,释放出放射性32P和Ag2S纳米点,通过近距离放射治疗和光热治疗的协同作用,增强肿瘤细胞消除和细菌杀灭效果。
此外,局部超高温、放射效应以及GelMA和HA基质的生物降解促进了无疤痕的创伤愈合,减少了炎症并促进了肉芽组织形成、胶原沉积和血管生成,从而实现了无疤痕的伤口愈合。因此,GM-Ag2S/Ca32P微针贴片代表了一种多功能策略,用于应对黑色素瘤复发和感染性创伤,展现出在术后临床应用中的巨大前景。
文献名称:Biomineralized Nanocomposite-Integrated Microneedle Patch for Combined Brachytherapy and Photothermal Therapy in Postoperative Melanoma Recurrence and Infectious Wound Healing
Chemical Engineering Journal
抗炎和抗氧化特性的光热效应增强的抗菌水凝胶促进感染伤口愈合
感染性伤口愈合过程中,细菌感染、持续的氧化应激和长期炎症是主要的障碍。开发一种能够有效消除细菌、减少氧化应激、缓解炎症并调节免疫微环境的多功能伤口敷料具有重要的临床意义。
2025年3月8日,期刊Chemical Engineering Journal报道研究人员开发一种含有表没食子儿茶素没食子酸酯(EGCG)和Ag2S@MoS2纳米片的可注射多功能水凝胶,具有优异的抗炎、抗氧化能力和协同增强的抗菌能力,可通过调节巨噬细胞极化,促进感染伤口的愈合。
在该项工作中,研究人员通过酚醛缩合反应将EGCG接枝到氧化海藻酸钠(OAlg)上得到氧化海藻酸钠-EGCG复合物(OAE),然后将Ag2S@MoS2纳米片引入OAE和羧甲基壳聚糖(CMCS)的水凝胶中,形成具有光热效应的多功能水凝胶(NSOAEC凝胶)。该NSOAEC凝胶在近红外辐射下表现出良好的光热活性,自由基清除实验证明,OAE能够有效清除超氧阴离子(O2-)、ABTS和DPPH自由基,表现出优异的抗氧化性能。
进一步的体外研究表明,NSOAEC凝胶可有效缓解细胞中的氧化应激,降低炎症因子的表达并增强抗炎因子的表达,并促进巨噬细胞从M1向M2的极化。由于Ag2S@MoS2纳米片具有优异的光热转换效率,使得NSOAEC凝胶在NIR照射下表现出协同抗菌效应,能够有效杀死大肠杆菌和金黄色葡萄球菌。
本研究将生物活性分子与光热效应相结合,制备了一种多功能NSOAEC凝胶,协同增强抗菌和免疫调节能力,为细菌感染创面的处理提供了一种新的治疗策略。
文献名称:Photothermal effect-enhanced antibacterial hydrogel with anti-inflammation and anti-oxidation properties: Macrophage polarization promotes infected wound healing
产品推荐
XF360
硫化银量子点
浓度:0.1 mg/mL
溶剂:水
直径:3-10 nm
外观:棕色溶液
稳定剂:牛血清白蛋白(BSA)
先丰纳米光热材料推荐
产品编号 |
产品名称 |
升温度数(实测数据) |
XFK01 |
碳化钛(Ti3C2Tx) MXene多层纳米片 |
52℃ |
XFK41-1 |
碳化钛(Ti3C2Tx) MXene纳米片 |
52℃ |
XF019-1 |
单层石墨烯分散液 |
60℃ |
XFM01 |
多壁碳纳米管 |
52℃ |
XFS22 |
超高纯大比表面积单壁碳纳米管 |
56℃ |
XFD01 |
双壁碳纳米管 |
52℃ |
XFP03 |
有序介孔碳CMK-3 |
41℃ |
XFP12 |
介孔碳球 |
38℃ |
XF207 |
黑磷纳米片分散液 |
40℃ |
XF283 |
紫磷晶体粉末 |
42℃ |
XF021 |
石墨烯纳米片 |
49℃ |
XF182-1 |
高质量薄层石墨烯 |
51℃ |
XF053 |
高纯鳞片石墨 |
47.1℃ |
XF215 |
石墨烯量子点发红光 |
57℃ |
XFF52 |
MOF-545 |
40℃ |
如您想了解更多光热材料的相关资料,可关注“先丰纳米”公众号,将您的要求发送到对话框,会有技术专家回复您,您也可以拨打电话025-68256996咨询~

01
充值大返利—多倍积分or高额返利
02
定制服务—满足个性化材料需求